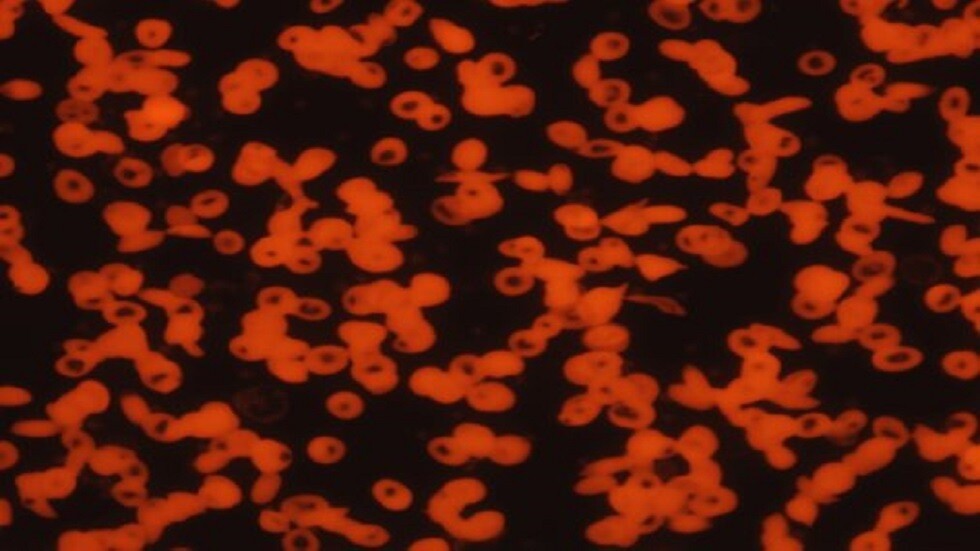
مواد غذائية لزيادة الهيموغلوبين

Stories
-
الحرب على إيران
RT STORIES
"فارس": هجمات أمريكية‑إسرائيلية على منشآت طاقة في أصفهان وخرمشهر
#اسأل_أكثر #Question_MoreRT STORIES
مسؤول أمريكي يوضح قرار ترامب بشأن وقف الهجمات على منشآت الطاقة الإيرانية
#اسأل_أكثر #Question_MoreRT STORIES
فون دير لاين: طائرة استطلاع أسترالية عملت على حماية أوكرانيا موجودة الآن في الخليج
#اسأل_أكثر #Question_MoreRT STORIES
تاكايتشي: اليابان ستبدأ الضخ من مخزوناتها النفطية اعتبارا من الخميس
#اسأل_أكثر #Question_MoreRT STORIES
واشنطن تدرس نشر 3000 مظلي من الفرقة 82 للسيطرة على جزيرة خارك الإيرانية
#اسأل_أكثر #Question_MoreRT STORIES
لحظة بلحظة.. الحرب الأمريكية الإسرائيلية على إيران بيومها الـ25: فتح باب الحوار على وقع المواجهات
#اسأل_أكثر #Question_MoreRT STORIES
بيان للخارجية الإيرانية عن المفاوضات مع واشنطن
#اسأل_أكثر #Question_More
الحرب على إيران
-
ضربات إسرائيلية على لبنان
RT STORIES
لحظة بلحظة.. غارات عنيفة على الضاحية الجنوبية واشتباكات في الجنوب
#اسأل_أكثر #Question_MoreRT STORIES
الصحة اللبنانية: مقتل شخصين وإصابة 5 بغارة إسرائيلية على بلدة بشامون بقضاء عاليه بجبل لبنان
#اسأل_أكثر #Question_MoreRT STORIES
سقوط قتلى وجرحى جراء غارة إسرائيلية على لبنان
#اسأل_أكثر #Question_MoreRT STORIES
إسرائيل تعلن أسر مقاتلين اثنين من "قوة الرضوان" في جنوب لبنان
#اسأل_أكثر #Question_MoreRT STORIES
الصحة اللبنانية: 10 قتلى و90 مصابا اليوم وارتفاع حصيلة الحرب إلى 1039 قتيلا و2876 جريحا منذ 2 مارس
#اسأل_أكثر #Question_More
ضربات إسرائيلية على لبنان
-
نبض الملاعب
RT STORIES
القضاء يحسم ملف فساد قديم.. 6 سنوات سجن لرئيس ناد مصري سابق
#اسأل_أكثر #Question_MoreRT STORIES
"ستوري" بـ20 مليون دولار.. جورجينا تنشر صورة مثيرة مع رونالدو
#اسأل_أكثر #Question_MoreRT STORIES
تخليد اسم سيمونيان أسطورة "أرارات" في العاصمة الأرمنية يريفان
#اسأل_أكثر #Question_More
نبض الملاعب
-
العملية العسكرية الروسية في أوكرانيا
RT STORIES
خبير عسكري: القوات الأوكرانية تنقل منظومات دفاع جوي من الخطوط الأمامية لحماية مقر إقامة زيلينسكي
#اسأل_أكثر #Question_MoreRT STORIES
زاخاروفا: روسيا لم ترفض قط التفاوض حول أوكرانيا
#اسأل_أكثر #Question_MoreRT STORIES
الدفاع الروسية: إسقاط 67 طائرة مسيرة أوكرانية فوق المناطق الروسية
#اسأل_أكثر #Question_MoreRT STORIES
ألمانيا ستسلم أوكرانيا 15 ألف طائرة مسيرة اعتراضية
#اسأل_أكثر #Question_More
العملية العسكرية الروسية في أوكرانيا
-
فيديوهات
RT STORIES
لحظة اصطدام طائرة إير كندا بشاحنة إطفاء في مطار لاغوارديا بنيويورك
#اسأل_أكثر #Question_MoreRT STORIES
صواريخ تحمل صورة ترامب ورسالة مكتوبة.. مشاهد لإطلاق الموجة الـ76 من عملية "الوعد الصادق 4"
#اسأل_أكثر #Question_MoreRT STORIES
أمطار غزيرة وعواصف رعدية تجتاح الإمارات وسلطنة عمان
#اسأل_أكثر #Question_MoreRT STORIES
حاملة الطائرات "جيرالد فورد" تصل جزيرة كريت بعد حريق هائل على متنها في البحر الأحمر
#اسأل_أكثر #Question_MoreRT STORIES
إسرائيل.. دمار واسع في ديمونا بعد استهدافها بصاروخ إيراني
#اسأل_أكثر #Question_MoreRT STORIES
معركة بروث البقر في ولاية هندية خلال مهرجان رأس السنة
#اسأل_أكثر #Question_MoreRT STORIES
العثور على صاروخ سقط في ريف القنيطرة جنوب سوريا
#اسأل_أكثر #Question_More
فيديوهات
-
نيبينزيا: السلطات الأوكرانية لا تهتم بمفاوضات السلام
RT STORIES
نيبينزيا: السلطات الأوكرانية لا تهتم بمفاوضات السلام
#اسأل_أكثر #Question_More
ماذا يحدث عند تناول لحم البقر يوميا؟
أعلنت الدكتورة إيرينا ريل، خبيرة التغذية الروسية، أن لحم البقر يساعد على إنتاج هرمون التستوستيرون المفيد لمرضى السكري.
وكشفت الخبيرة في حديث لوكالة نوفوستي الروسية للأنباء، ما الذي يحدث في الجسم في حالة تناول لحم البقر بانتظام.
مواد غذائية لزيادة الهيموغلوبين
وتقول، "لحم البقر وخاصة لحم العجل، يحتوي على نسبة عالية من الحديد، لذلك هو ضروري لمن يعاني من نقص الهيموغلوبين وفقر الدم. ويحتوي لحم البقر أيضا على بروتينات نوعية وأحماض أمينية، ضرورية لإنتاج الكولاجين، الضروري للجلد والمفاصل والأوعية والشعر".
وتضيف، "يساعد لحم البقر على إنتاج هرمون التستوستيرون، الضروري والمهم لصحة الرجال وحيويتهم. وأن البروتين النوعي في لحم البقر، يساعد على نمو الكتلة العضلية. كما أن احتواءه على نسبة عالية من البروتين وقلة الدهون فيه وعدم وجود الكربوهيدرات، يفيد أولئك الذين يرغبون في تخفيض وزنهم".
وتستطرد الخبيرة، "لحم البقر مفيد في النظام الغذائي لمرضى السكري. لأنه مصدر لفيتامينات مجموعة B (الضرورية لعمل الجهاز العصبي والمناعة). كما يحتوي على مادة التورين والزنك التي تساعد على تعزيز جهاز المناعة".
المصدر: نوفوستي
التعليقات